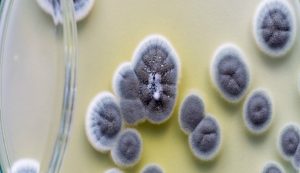

Health
Most People Who Think They Have a Penicillin Allergy Are Wrong
Are you allergic to penicillin? If so, are you sure about that? It’s surprisingly common for people to wrongly think
Are you allergic to penicillin? If so, are you sure about that? It’s surprisingly common for people to wrongly think

Key aspects of the aging of human cells can be reversed by new compounds. In a laboratory study of endothelial

Potential link between brain trauma and degenerative brain disease revealed A landmark study published in the journal “Traumatic brain injury

Radioactive Traces of Fukushima Have Been Found in Wine All The Way in California The radioactive fallout of the Fukushima

Pharmaceutical Companies Are Backing Away From a Threat That Could Kill 10 Million a Year by 2050 Just two years

Targeting headaches and tumors with nano-submarines Scientists at the Mainz University Medical Center and the Max Planck Institute for Polymer